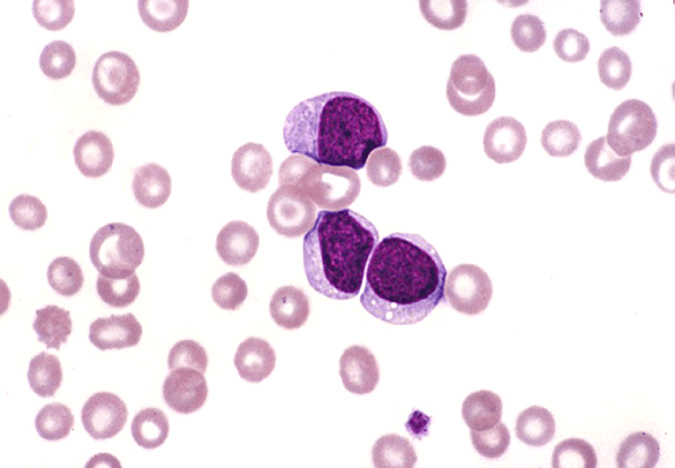
这3种白细胞肿瘤疾病的细胞学发现,临床意义与预后,你都掌握了吗?

白细胞xt细胞

为什么有些疾病引起白细胞增多?
图片尺寸1200x900
显微镜下的各种白细胞0505
图片尺寸1280x1706
镜下白细胞
图片尺寸1080x1440
显微镜下的各种白细胞0505
图片尺寸1280x1706
分不清各种白细胞?16615张卡片助你升级!
图片尺寸1440x1920
显微镜下的各种白细胞0505
图片尺寸1280x1706
请你看白细胞
图片尺寸1080x1081
镜下白细胞辨别
图片尺寸2048x1536
这3种白细胞肿瘤疾病的细胞学发现,临床意义与预后,你都掌握了吗?
图片尺寸642x513
这3种白细胞肿瘤疾病的细胞学发现,临床意义与预后,你都掌握了吗?
图片尺寸642x514
镜下白细胞辨别
图片尺寸2048x1536
这3种白细胞肿瘤疾病的细胞学发现,临床意义与预后,你都掌握了吗?
图片尺寸675x468
同样的白细胞危急值,同样的淋巴细胞比例升高,看似相同,实则不然
图片尺寸662x655
这3种白细胞肿瘤疾病的细胞学发现,临床意义与预后,你都掌握了吗?
图片尺寸675x507
白细胞检验
图片尺寸1080x1439
检验人,莫让不幸中的幸运成为不幸|白血病|骨髓|粒细胞|白细胞|外周血
图片尺寸660x660
骨髓|活检|红细胞|白细胞|恶性肿瘤_网易订阅
图片尺寸660x362
骨髓|血液病|性疾病|粒细胞|白细胞_网易订阅
图片尺寸462x474
镜下所见:进一步观察散点图,图形如下所示,wdf散点图出现原始细胞区域
图片尺寸962x722
似"鹿角"状产板巨产大量的血小板骨髓片:血片:白细胞数大致正常,以
图片尺寸660x452